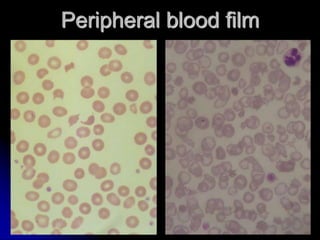
Peripheral blood film

This document provides an overview of bleeding and coagulation disorders. It discusses the components of hemostasis including primary hemostasis mediated by platelets and vessel walls and secondary hemostasis involving the coagulation factors. Common disorders are described such as platelet disorders, hemophilia, and von Willebrand disease. Clinical features and laboratory evaluation including screening coagulation tests are reviewed. Specific conditions like immune thrombocytopenic purpura and thrombotic thrombocytopenic purpura are then explained in more detail covering etiology, pathogenesis, clinical presentation, and diagnosis.